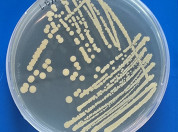
MiSeed

Droevendaalsesteeg 10
6708 PB Wageningen
The Netherlands
Microbial communities are largely shaped by chemical interaction networks mediated by specialized water-soluble and/or volatile metabolites
The focus of my current research is to understand the fundamental mechanisms of microbial chemical interactions and communication. Secondary metabolites (both volatile and water-soluble) play an important role in microbial interactions, e.g. as signalling compounds for communication or as suppressive agents in interference competition.
Using omics-based tools, advanced analytical chemistry and novel imaging techniques, my research aims to decipher, explore and exploit the so far unknown belowground microbe-microbe and plant-microbe chemical interactions and communication. Understanding the belowground inter-kingdom (bacteria, protists, fungi, plants) interactions is crucial for assessing the functioning of soil ecosystems, which underpins soil and plant health.
Volatile organic compounds (VOCs) emitted by soil bacteria influence interactions with other soil microbes and plants. While their potential as plant growth promoters is well recognized, their role in promoting plant resilience to abiotic stress and the underlying molecular mechanisms remain poorly understood. Here, we investigate the role of Pseudomonas VOCs in enhancing plant resilience to drought stress Arabidopsis seedlings were exposed to VOCs emitted by Pseudomonas strains under control and osmotic stress conditions. Plant biomass and root architecture were evaluated. Root transcriptomics analysis was performed and validated using Arabidopsis mutants and metabolomics. Volatile organic compounds effects were also tested on soil-grown Brassica oleracea and on its rhizosphere microbiome. Pseudomonas VOCs promoted plant growth under both axenic and soil conditions in A. thaliana and in B. oleracea, and under control and drought conditions. Transcriptomics, metabolomics, and functional analysis revealed interactions between Pseudomonas VOCs, glucosinolates, and ABA signalling, as well as a positive association between VOC exposure and coumarin biosynthesis. VOC treatment also reshaped the rhizosphere microbiome under drought, leading to a community composition more similar to that of well-watered plants. Overall, Pseudomonas VOCs promote plant growth under drought conditions, linked to root transcriptional reprogramming and direct or indirect microbiome modulation.
Pseudomonadota (formerly Proteobacteria) commonly use a contact independent cell–cell communication system known as quorum sensing (QS) mediated by N-acyl-homoserine lactone (AHL) signal molecules. The canonical AHL QS system involves a luxI-family gene, which encodes an AHL synthase, and a luxR-family gene, which encodes a transcriptional regulator responsive to the cognate AHL(s). This study involves the AHL QS system of Enterobacter asburiae AG129, a root associated strain isolated from rice (Oryza sativa). Enterobacter asburiae AG129 produces the N-butanoyl homoserine lactone (C4-AHL) signal molecule. Genome sequencing of strain AG129 revealed the presence of a canonical AHL QS system, comprising genetically adjacent easI-like and easR-like genes. A genomic easI knockout mutant was no longer able to produce AHLs, but the in-trans complementation with a plasmid carrying the easI gene restored the AHL production. QS mediated by AHLs in AG129 was found to influence rice root colonization, and secretome analysis highlighted a significant regulatory role in the expression of Type VI secretion system (T6SS) proteins. Gas chromatography–mass spectrometry analysis identified 16 volatile organic compounds (VOCs) that were more abundantly emitted by the wild-type strain compared to the easI mutant. Overall, our findings suggest that AHL-based QS in E. asburiae AG129 positively regulates T6SS expression and VOC production, while negatively affecting root colonization and motility. This study is among the first to explore the role of QS signaling in a bacterial root-endophyte, providing evidence of a connection between QS activity and the ability of the bacterium to inhabit, compete and colonize the plant root endosphere.
The fungal pathogen Botrytis cinerea causes significant damage to aboveground plant parts, but its impact on root chemistry and microbiome composition is less understood. This study investigated how B. cinerea foliar infection influences the root volatilome and microbiome of two tomato genotypes: wild Solanum pimpinellifolium and domesticated Solanum lycopersicum var. Moneymaker. In the absence of infection, wild tomato roots emitted higher levels of monoterpenes such as α-pinene and terpinene compared to domesticated tomato roots. The fungal infection induced elevated levels of benzyl alcohol and benzofuran in the root headspace and/or rhizosphere of both genotypes, alongside genotype-specific changes. Multivariate analyses revealed that B. cinerea significantly altered bacterial and fungal community compositions in the rhizosphere and rhizoplane, with stronger bacterial community shifts in the rhizoplane. Taxa depletion and enrichment were observed, particularly among Proteobacteria and Ascomycota. Mantel tests showed significant correlations between rhizoplane bacterial community compositions and root-associated volatilome. Notably, enriched bacterial taxa such as Pelomonas and Comamonadaceae positively correlated with benzyl alcohol and benzofuran levels in the root volatilome. These findings demonstrate that B. cinerea foliar infection might induce profound changes in root-associated volatilome and microbiome composition, highlighting its systemic effects on plant root chemistry and microbiome composition.
Bacterial volatile organic compounds can play a significant role in antagonistic interactions. Enhancing the production of bacterial volatiles that suppress the growth of soil-borne phytopathogenic fungi, has perspective as a sustainable disease control strategy. In the present study, we explored the potential of stimulating Burkholderia AD24 and Paenibacillus AD87 to produce volatiles that suppress the growth of the plant pathogenic fungi Fusarium culmorum PV and Rhizoctonia solani AG2.2IIIb. We provided the bacterial strains with a mixture of amino acids that can serve as precursor molecules in metabolic routes leading to emission of suppressive bacterial volatiles. Only Burkholderia AD24 was stimulated to produce a volatile blend that led to higher suppression of both pathogens. Subsequent analysis of the volatile composition emitted by Burkholderia AD24 in the presence of amino acids, showed higher abundance of antifungal compounds, including sulfur compounds (DMDS), pyrazines (2,5-dimethyl pyrazine) and carbohydrates (3-methyl-1-butanol). Follow-up trials with single amino acids revealed a pathogen specific response effect. When Burkholderia AD24 was cultivated in the presence of glutamine and asparagine, the emitted volatile blend suppressed the growth of F. culmorum, whereas when cultivated in the presence of glycine, glutamine, arginine and lysine the volatile blend suppressed the growth of R. solani. Analysis of the volatile blend composition showed differences between the amino acid treatments. Our findings show that amino acid precursor molecules can stimulate the production of fungistatic volatiles but the sensitivity of the fungal pathogens to these bacterial volatiles varies. This should be considered in future application strategies.
Microplastic (MP) pollution constitutes an emerging type of pollution threatening both aquatic and terrestrial ecosystems. The impact on aquatic ecosystems has been extensively studied, but the effect on terrestrial ecosystems and their inhabitants is mostly under-explored. In this study, we explored the effect of MP pollution on gut bacterial microbiome of endogeic (Aporrectodea caliginosa) and anecic (Lumbricus terrestris) earthworms. The experiments were performed in sandy soil with 0.2% of low-density polyethylene MPs (LDPE MPs). We observed that the endogeic earthworms had 100% survival, while anecic earthworms survived 25 days in the control (i.e. in absence of MPs) and 21 days in the treatment with LDPE MPs. The main driver of shifts in the diversity and composition of the bacterial communities in the gut of tested earthworms was the lifestyle of the worms, followed by the presence of MPs. The bacterial microbiome diversity was significantly different among the two types of earthworms, and the highest bacterial diversity was found in the gut of the endogeic earthworms. The effect of MPs on gut bacterial microbiome was clearly observed in the changes in the relative abundance of several phyla and families of the bacterial communities in both types of earthworms, although it was most evident in the anecic earthworms. The Actinobacteriota, Proteobacteria, and Firmicutes were the main groups enhanced in the MP treatments, suggesting enrichment of the bacterial communities with potential plastic degraders.
Natural ecosystems harbor a huge reservoir of taxonomically diverse microbes that are important for plant growth and health. The vast diversity of soil microorganisms and their complex interactions make it challenging to pinpoint the main players important for the life support functions microbes can provide to plants, including enhanced tolerance to (a)biotic stress factors. Designing simplified microbial synthetic communities (SynComs) helps reduce this complexity to unravel the molecular and chemical basis and interplay of specific microbiome functions. While SynComs have been successfully employed to dissect microbial interactions or reproduce microbiome-associated phenotypes, the assembly and reconstitution of these communities have often been based on generic abundance patterns or taxonomic identities and co-occurrences but have only rarely been informed by functional traits. Here, we review recent studies on designing functional SynComs to reveal common principles and discuss multidimensional approaches for community design. We propose a strategy for tailoring the design of functional SynComs based on integration of high-throughput experimental assays with microbial strains and computational genomic analyses of their functional capabilities.
Plants produce volatile organic compounds that are important in communication and defense. While studies have largely focused on volatiles emitted from aboveground plant parts upon exposure to biotic or abiotic stresses, volatile emissions from roots upon aboveground stress are less studied. Here, we investigated if tomato plants under insect herbivore attack exhibited a different root volatilome than non-stressed plants, and whether this was influenced by the plant’s genetic background. To this end, we analyzed one domesticated and one wild tomato species, i.e., Solanum lycopersicum cv Moneymaker and Solanum pimpinellifolium, respectively, exposed to leaf herbivory by the insect Spodoptera exigua. Root volatiles were trapped with two sorbent materials, HiSorb and PDMS, at 24 h after exposure to insect stress. Our results revealed that differences in root volatilome were species-, stress-, and material-dependent. Upon leaf herbivory, the domesticated and wild tomato species showed different root volatile profiles. The wild species presented the largest change in root volatile compounds with an overall reduction in monoterpene emission under stress. Similarly, the domesticated species presented a slight reduction in monoterpene emission and an increased production of fatty-acid-derived volatiles under stress. Volatile profiles differed between the two sorbent materials, and both were required to obtain a more comprehensive characterization of the root volatilome. Collectively, these results provide a strong basis to further unravel the impact of herbivory stress on systemic volatile emissions.
Dissolved oceanic CO2 concentrations are rising as result of increasing atmospheric partial pressure of CO2 (pCO2), which has large consequences for phytoplankton. To test how higher CO2 availability affects different traits of the toxic dinoflagellate Alexandrium ostenfeldii, we exposed three strains of the same population to 400 and 1,000 µatm CO2, and measured traits including growth rate, cell volume, elemental composition, 13C fractionation, toxin content, and volatile organic compounds (VOCs). Strains largely increased their growth rates and particulate organic carbon and nitrogen production with higher pCO2 and showed significant changes in their VOC profile. One strain showed a significant decrease in both PSP and cyclic imine content and thereby in cellular toxicity. Fractionation against 13C increased in response to elevated pCO2, which may point towards enhanced CO2 acquisition and/or a downscaling of the carbon concentrating mechanisms. Besides consistent responses in some traits, other traits showed large variation in both direction and strength of responses towards elevated pCO2. The observed intraspecific variation in phenotypic plasticity of important functional traits within the same population may help A. ostenfeldii to negate the effects of immediate environmental fluctuations and allow populations to adapt more quickly to changing environments.
In disease-suppressive soils, microbiota protect plants from root infections. Bacterial members of this microbiota have been shown to produce specific molecules that mediate this phenotype. To date, however, studies have focused on individual suppressive soils and the degree of natural variability of soil suppressiveness remains unclear. Here, we screened a large collection of field soils for suppressiveness to Fusarium culmorum using wheat ( Triticum aestivum) as a model host plant. A high variation of disease suppressiveness was observed, with 14% showing a clear suppressive phenotype. The microbiological basis of suppressiveness to F. culmorum was confirmed by gamma sterilization and soil transplantation. Amplicon sequencing revealed diverse bacterial taxonomic compositions and no specific taxa were found exclusively enriched in all suppressive soils. Nonetheless, co-occurrence network analysis revealed that two suppressive soils shared an overrepresented bacterial guild dominated by various Acidobacteria. In addition, our study revealed that volatile emission may contribute to suppression, but not for all suppressive soils. Our study raises new questions regarding the possible mechanistic variability of disease-suppressive phenotypes across physico-chemically different soils. Accordingly, we anticipate that larger-scale soil profiling, along with functional studies, will enable a deeper understanding of disease-suppressive microbiomes.